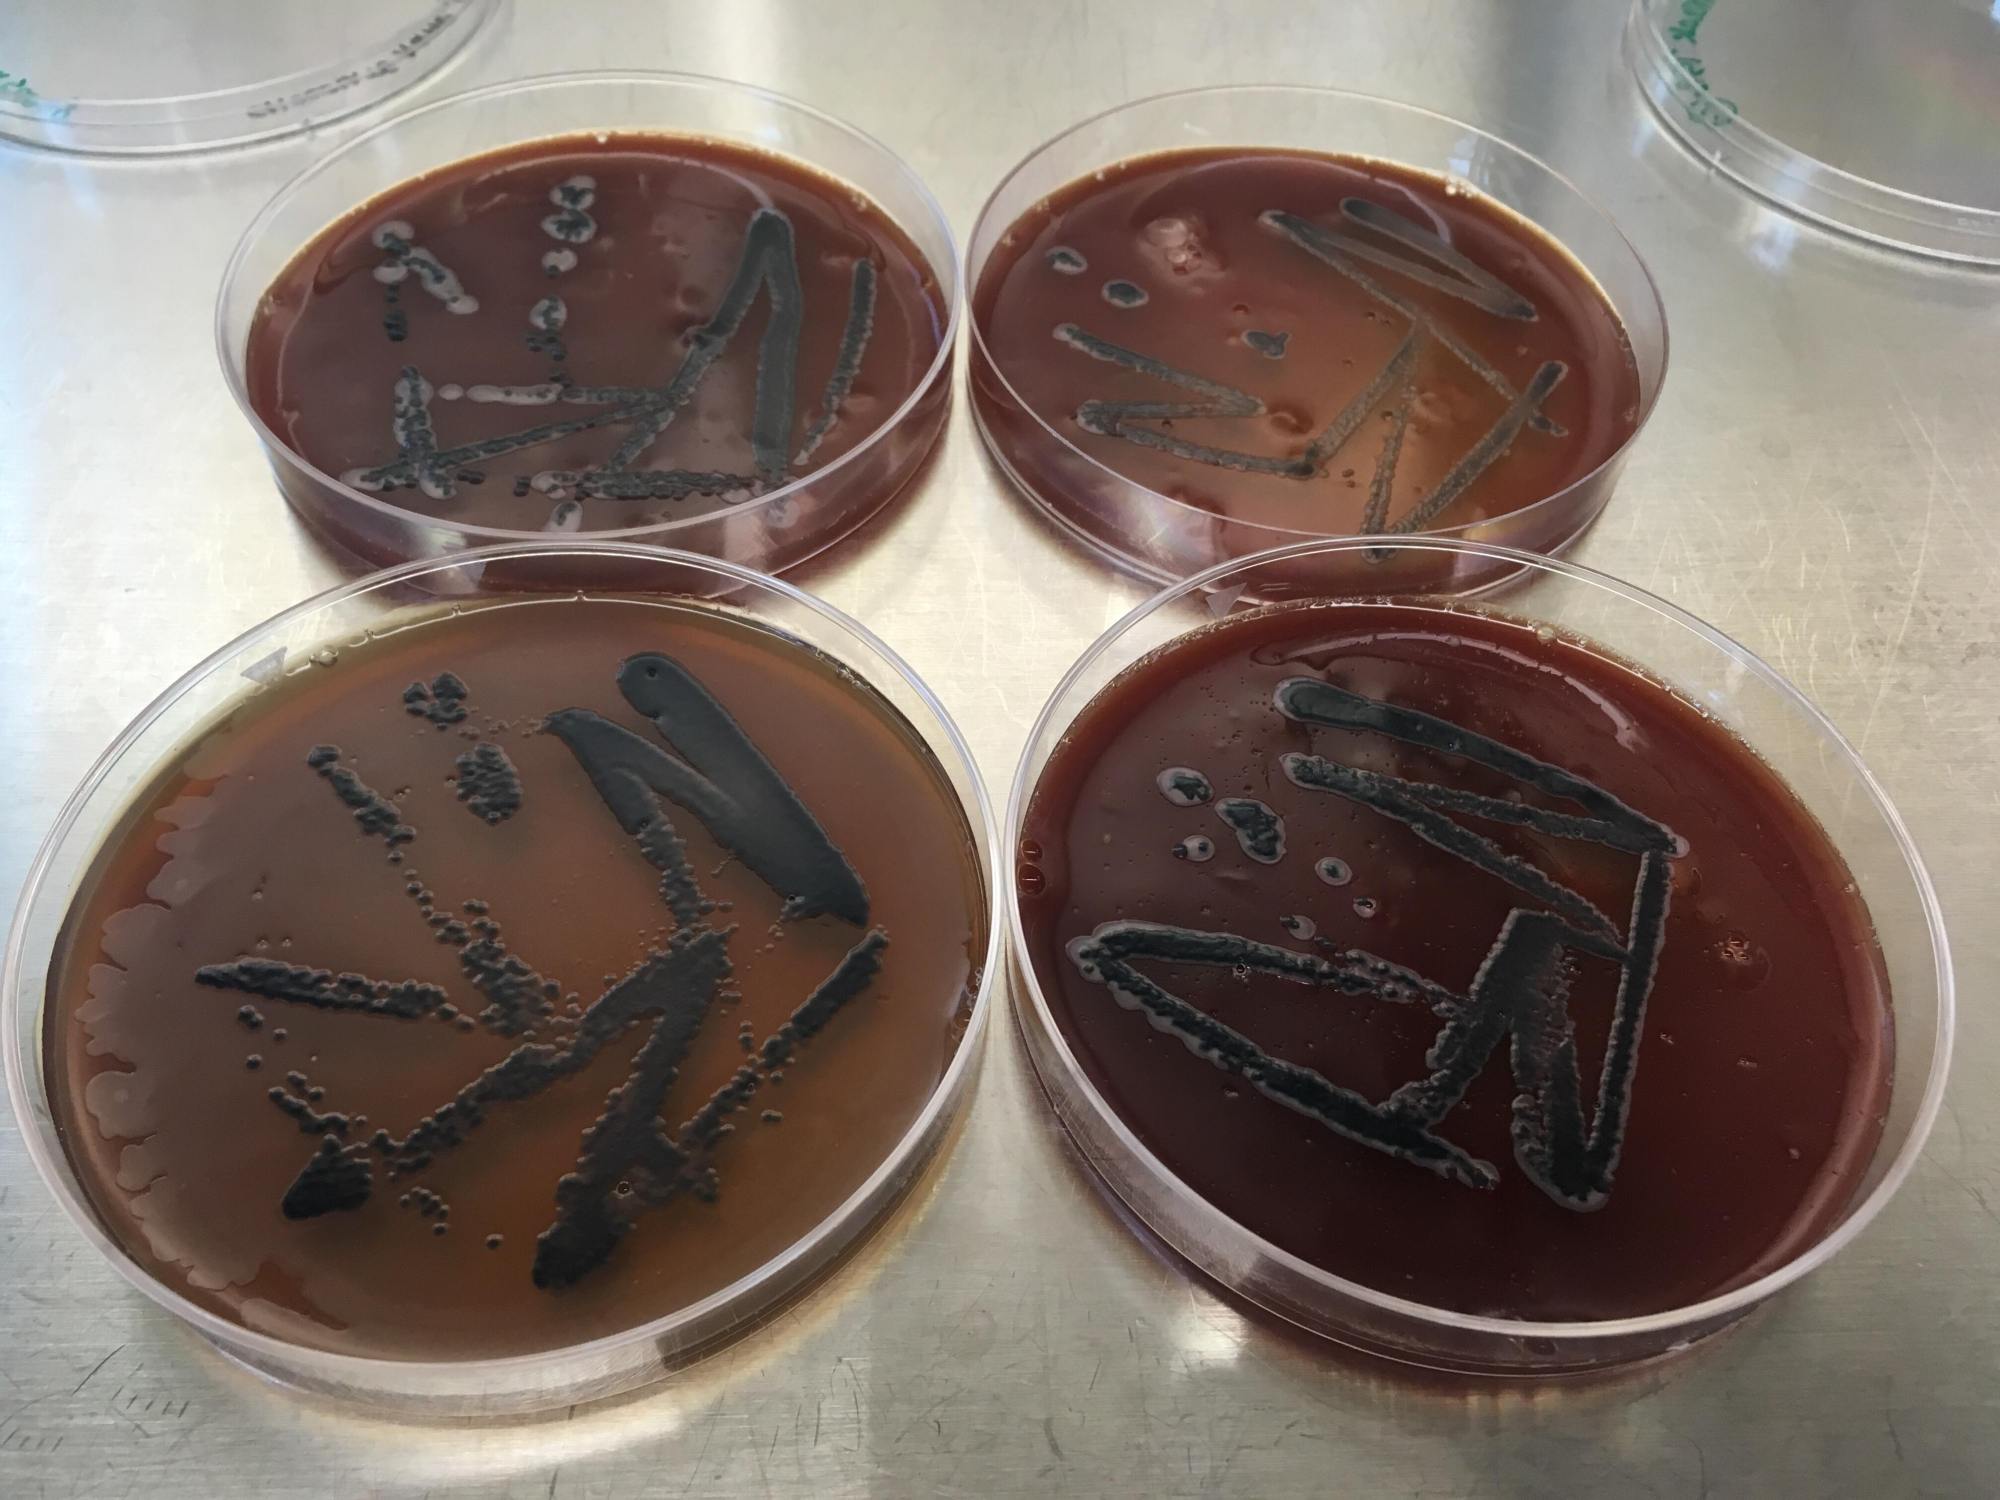

An interview with WhiteFeather is featured in MIT’s Immerse Magazine, as part of a spotlight on MIT Open Documentary Lab’s Co-Creation Studio.
Read the full interview here.
An interview with WhiteFeather is featured in MIT’s Immerse Magazine, as part of a spotlight on MIT Open Documentary Lab’s Co-Creation Studio.
Read the full interview here.